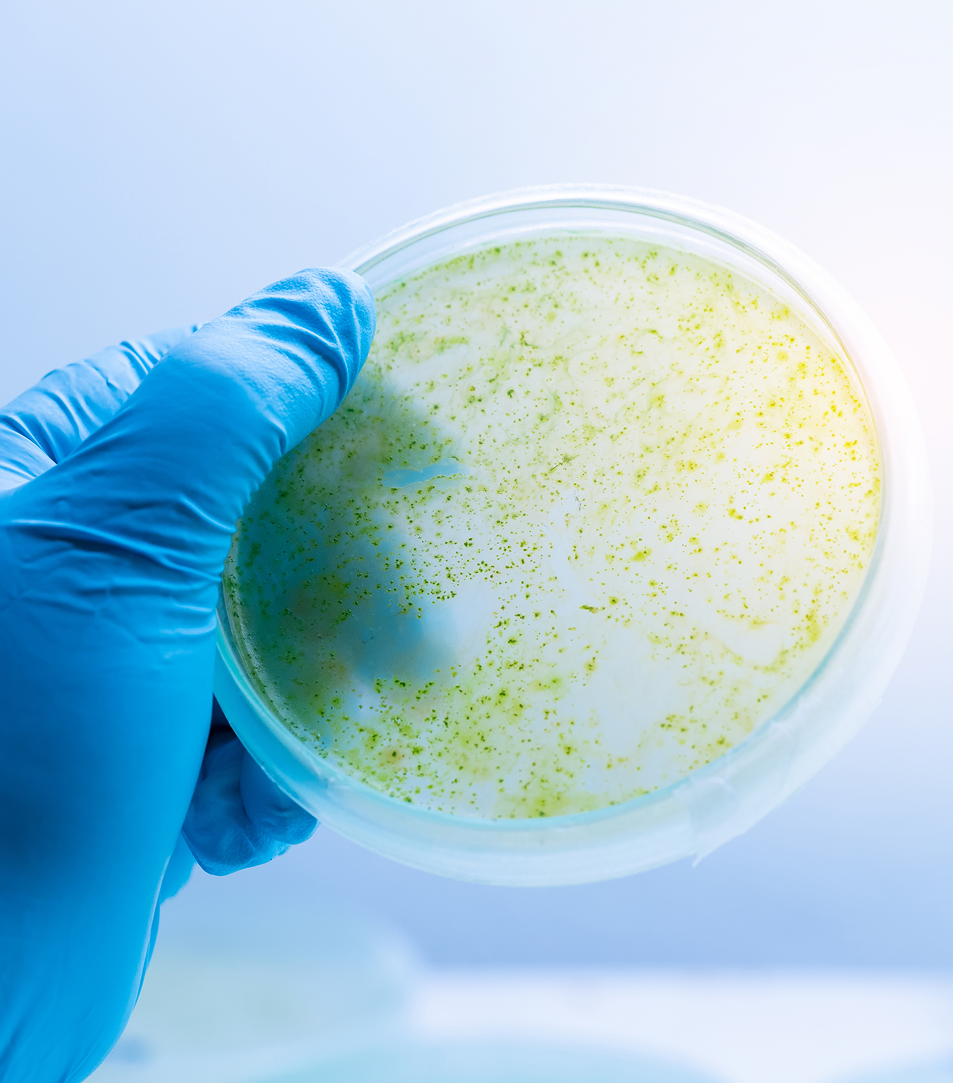

Ingredient Development
Turn your ingredient vision into a scalable, market-ready product. Whether for food, animal nutrition, nutraceuticals, or cosmetics from botanical extracts, we provide the expertise and infrastructure to take your concept from idea to large-scale production.


Broad Applications for Every Market
From plant-based proteins to marine oils, algae extracts to botanicals, we create ingredients that meet your performance, nutritional, and sustainability goals.
End-to-End Capabilities
Our vertically integrated process means we can handle every step of development—from sourcing and extraction to purification, modification, valorization, and final delivery—so you get better timelines, consistent quality, and fewer supply chain issues.


Expertise Across Material

Biomass
Algae, yeast, bacteria, and mushrooms

Plant-Based
Pulses and other legumes, oilseeds, cereals, pseudocereals, nuts, and leaves

Botanical
Roots, seeds, flowers, and whole plants

Marine
Fish and algal soruces

Upstream Processing
We prepare and extract ingredients with precision, ensuring maximum yield and quality for your raw materials.
- Seed cleaning and pre-treatments
- Seed dehulling and milling
- De-oiling for sources with high oil content (solvent or aqueous using 3-phase separation)
Downstream Processing
We refine and transform your extracted materials into high-value, functional ingredients.
- Extraction
+ Alkaline extraction or salt-and- – enzyme-assisted - Purification via precipitation, ultrafiltration, or nanofiltration
- Ingredient modification via hydrolysis and chemical modifications
- Encapsulation
- Spray drying or freeze drying
Precision Fermentation Support
We offer specialized downstream processing for the precision fermentation space, including the disruption of single-cell organisms (algae, yeast, and bacteria) and advanced purification and separation of bioactive compounds. These capabilities enable the recovery of high-value ingredients for food, nutraceutical, pharmaceutical (intermediate ingredients), and industrial applications.


Non-Food Material Extraction and Development
Our capabilities go beyond food and nutraceuticals. We also work with non-food material to extract and develop specialized compounds for industrial, technical, cosmetics, and other innovative applications.
Built for Scale
We specialize in large-scale extraction and ingredient manufacturing, ensuring your product is ready for commercial launch without compromising on quality.



Innovation Through Collaboration
Our R&D team works alongside you to refine formulas, enhance performance, and develop ingredients that stand out in your market.

Interested in Working With Us?
Begin your ingredient development journey with guidance from our technical specialists.






